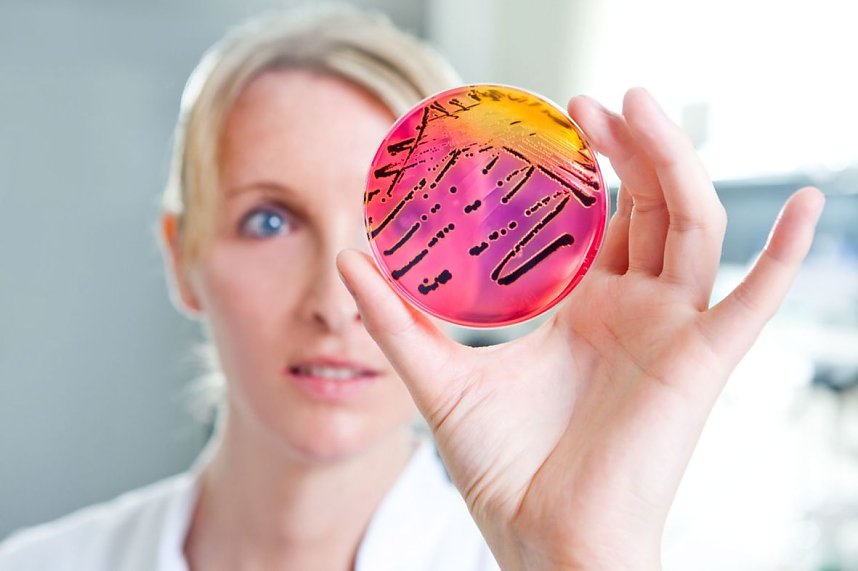
Keime, Keime, Keime

nnz/kn-Tipp: Sie sind überall
← zurück – Bild 3 von 3 – weiter → Keime, Keime, Keime (Foto: SGS INSTITUT FRESENIUS)
Keime, Keime, Keime (Foto: SGS INSTITUT FRESENIUS)
Alle Texte, Bilder und Grafiken dieser Web-Site unterliegen dem Urheberrecht. Weiterverbreitung nur mit schriftlicher Genehmigung von nnz-online.de.


